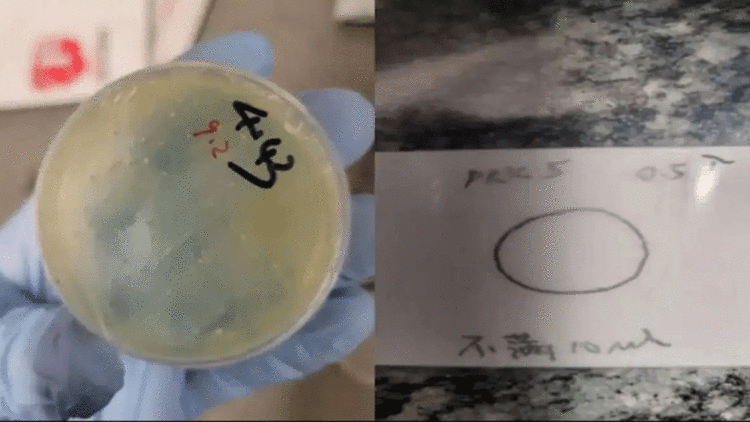

വാഷിംഗ്ടണ്: ജൈവ വസ്തുക്കള് അനധികൃതമായി കടത്തിയ ചൈനീസ് വനിത യുഎസിൽ അറസ്റ്റില്. ഗവേഷക. വിദ്യാര്ത്ഥിനി ചെങ്സ്വാന് ഹാനാണ് എഫ്ബിഐയുടെ പിടിയിലായത്. ഇറക്കുമതിക്ക് പ്രത്യേക അനുമതി ആവശ്യമുള്ള ജൈവ വിരകളാണ് ഇവർ കടത്താൻ ശ്രമിച്ചത്. ദിവസങ്ങൾക്ക് മുമ്പ് രണ്ട് ചൈനീസ് ശാസ്ത്രജ്ഞർ സമാന രീതിയിൽ പിടിയിലായിരുന്നു. അമേരിക്കൻ ഗവേഷണങ്ങളെ ദുര്ബലപ്പെടുത്താനുള്ള ചൈനീസ് കമ്യൂണിസ്റ്റ് പാർട്ടിയുടെ ശ്രമമാണ് ഇതിന് പിന്നിലെന്നും ശക്തമായി പ്രതിരോധിക്കുമെന്നും യുഎസ് മുന്നറിയിപ്പ് നൽകി.
പുസ്തകത്തിനുള്ളില് പ്രത്യേക അറയുണ്ടാക്കിയ അതിൽ ഒളിപ്പിച്ച നിലയിലായിരുന്നു വിരകളെന്നാണ് എഫ്ബിഐയെ വൃത്തങ്ങൾ നൽകുന്ന വിവരം. വുഹാനിലെ ഹ്വാസോങ് യൂണിവേഴ്സിറ്റി ഓഫ് സയന്സ് ആന്ഡ് ടെക്നോളജിയിലെ വിദ്യാര്ത്ഥിനിയാണ് അറസ്റ്റിലായ ചെങ്സ്വാന് ഹാന്. ജൂണ് എട്ടിന് ഡെട്രോയിറ്റ് മെട്രോപൊളിറ്റന് എയര്പോര്ട്ടില് വച്ചാണ് ഇവരെ കസ്റ്റഡിയിൽ എടുത്തത്.
ചൈനീസ് പൗരയുടെ അറസ്റ്റ് എഫ്ബിഐ ഡയറക്ടർ കാഷ് പട്ടേൽ സ്ഥിരീകരിച്ചു. ചൈനയിൽ നിന്നുള്ള ചെങ്സ്വന് ഹാനെ ജൈവ വസ്തുക്കള് യുഎസിലേക്ക് കടത്തിയതിന് അറസ്റ്റ് ചെയ്തിട്ടുണ്ട്. ഫെഡറൽ ഏജന്റുമാരോട് കള്ളം പറഞ്ഞ് രക്ഷപ്പടാനുള്ള ശ്രമം അവർ നടത്തി. ജൈവ കടത്തുമായി ബന്ധപ്പെട്ട് മൂന്നാമത്തയാളാണ് പിടിയിലാകുന്നത്. മിഷിഗൺ സർവ്വകലാശാലയിലെ ലാബിലേക്ക് നാട വിര ( Round worm) അടങ്ങിയ നാല് പാക്കുകൾ അയച്ചതായി കണ്ടെത്തിയിട്ടുണ്ട്, കാഷ് പട്ടേൽ വ്യക്തമാക്കി.
ഇത്തരം വിരകളെ കൊണ്ടുവരാൻ സർക്കാർ അനുമതി ആവശ്യമാണെന്ന് എഫ്ബിഐ കോടതിയിൽ അറിയിച്ചു. യുഎസിലേക്ക് വരുന്നതിന് ഏതാനും ദിവസങ്ങള്ക്ക് മുമ്പ് ഹാന് ഇലക്ട്രോണിക് ഉപകരണങ്ങളില് നിന്ന് വിവരങ്ങള് മായ്ച്ചതായും പ്രോസിക്യൂട്ടര്മാര് പറഞ്ഞു.